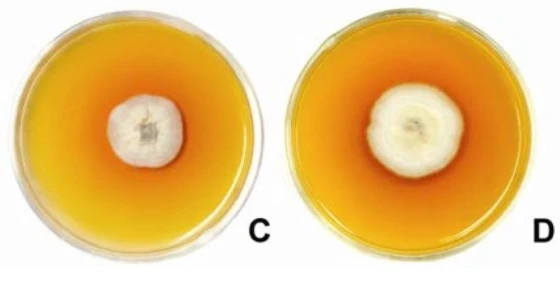
Khuẩn lạc và sắc tố của Gonatophragmium sp. được nuôi trong tối ở 28–30°C trên môi trường PDA

Triệu chứng
Bệnh thường xuất hiện khi cây kết thúc đẻ nhánh và chuyển sang phân hóa đòng, tức từ khi bắt đầu từ khi hình thành bông. Ban đầu, các vết bệnh trên lá xuất hiện dưới dạng các đốm nhỏ li ti màu vàng lục nhạt đến cam nhạt ở gốc phiến lá.

Khi bệnh phát triển, vết bệnh lan rộng dọc theo bẹ lá về phía ngọn lá, tạo thành các vệt và sọc đỏ. Các vết bệnh có thể bị hoại tử và hợp nhất, khiến lá có vẻ bị cháy sém. Các triệu chứng có thể bị nhầm lẫn với bệnh vàng cháy lá khác và gần như không thể phân biệt được với bệnh cháy lá do vi khuẩn ở giai đoạn nặng. Tuy nhiên, trong bệnh sọc đỏ, thường có một hoặc nhiều vết bệnh như vậy trên mỗi lá và chúng thể hiện đặc điểm là đốm màu vàng cam kết nối với một vệt kéo dài về phía ngọn lá.

Bệnh sọc đỏ, một bệnh mới nổi trên lúa, đã được ghi nhận trong những năm gần đây ở các hệ thống sản xuất lúa thâm canh tại vùng nhiệt đới châu Á. Ở Việt Nam, bệnh này còn được gọi là bệnh vàng lá, hội chứng vàng lá, và hội chứng vàng lá (20), còn ở Indonesia gọi là bệnh cháy lá màu cam do vi khuẩn.
Bệnh lần đầu được báo cáo tại Indonesia năm 1987, sau đó ở Campuchia, Lào, Malaysia, Philippines, Thái Lan và Việt Nam. Bệnh xuất hiện rải rác ở các quốc gia này, ngoại trừ Việt Nam, nơi nông dân ở vùng đồng bằng sông Mekong xem đây là một vấn đề bệnh hại quan trọng.

Triệu chứng điển hình của bệnh sọc đỏ trên đồng ruộng là các đốm màu vàng cam không có ranh giới rõ, có các vệt sọc kéo dài về phía chóp lá (A và B). Mặc dù phổ biến hơn trên phiến lá, các vết bệnh cũng xuất hiện trên bẹ lá và thân. Trong điều kiện đồng ruộng, triệu chứng thường xuất hiện từ giai đoạn trỗ đến chín của lúa.
Các triệu chứng này không giống với bất kỳ bệnh lúa nào khác; do đó đã có nhiều nỗ lực nhằm xác định nguyên nhân bệnh. Nấm Curvularia lunata và vi khuẩn như Acidovorax avenae subsp. avenae và một số loài Microbacterium chưa xác định đã được báo cáo có liên quan đến bệnh. Tuy nhiên, chưa có bằng chứng chắc chắn rằng bất kỳ sinh vật nào trong số này có thể tạo ra triệu chứng sọc đỏ điển hình trong điều kiện tự nhiên hoặc kiểm soát.
Nguyên nhân
Các triệu chứng trên thuộc chi Gonatophragmium gây ra. Mặc dù nấm có thể xuất hiện trên cây ngay từ giai đoạn cây con, nhưng các triệu chứng thường bắt đầu phát triển khi cây đến giai đoạn phân hóa đòng, bắt đầu từ khi hình thành bông.

Các yếu tố môi trường như nhiệt độ cao, độ ẩm tương đối cao, độ ẩm lá cao và lượng đạm cung cấp cao sẽ làm tăng sự phát triển của bệnh. Tác nhân gây bệnh xâm nhập vào mô thực vật và sản sinh ra độc tố được các gân lá vận chuyển về phía đầu lá, từ đó hình thành các vết sọc đặc trưng. Bệnh vàng lá chín sớm (còn gọi bệnh sọc bàng, bệnh sọc đỏ) là mối đe dọa tiềm tàng đối với sản xuất lúa ở Đông Nam Á và Ấn Độ đặc biệt là Việt Nam.

Dựa trên các đặc điểm hình thái của nấm, tác nhân gây bệnh sọc đỏ được xác định là một loài thuộc chi Gonatophragmium. Khuẩn lạc của loài này phát triển chậm, đạt đường kính trung bình 29,0 ± 0,9 mm sau khi ủ trên môi trường PDA trong 18 ngày ở nhiệt độ 28 đến 30 độ C.
Nấm này cạnh tranh yêu, có thể dễ dàng bị lấn át bởi các sinh vật hoại sinh khi lá bị nhiễm bệnh được ủ bằng phương pháp để ẩm mà không khử trùng. Sắc tố vàng cam được quan sát thấy trên môi trường PDA có sự phát triển của sợi nấm và trên giấy lọc có lá bị nhiễm bệnh, một đặc điểm độc đáo giúp phân lập nấm.

Biện pháp phòng trừ
Vui lòng liên hệ
Ghi chú: Bài viết có sử dụng thông tin từ nghiên cứu của F. A. Elazegui và cộng sự: “Tác nhân gây bệnh sọc đỏ trên lúa”, do Hiệp hội Bệnh học Thực vật Hoa Kỳ xuất bản năm 2004.
Biên soạn: Thạc sĩ. Phan Anh Thế




